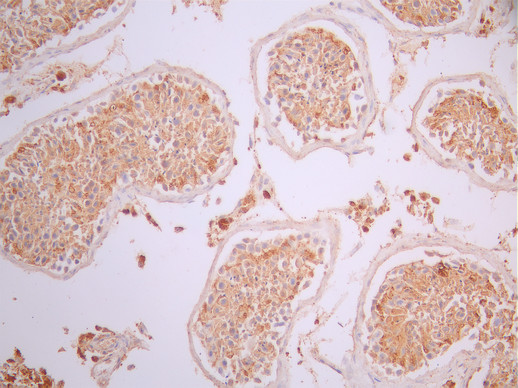

-
中文名稱:PDGFRB (rinucumab) Recombinant Monoclonal Antibody
-
貨號:CSB-RA017713MA1HU
-
規格:¥1320
-
圖片:
-
The Binding Activity of Human PDGFRB with Anti-PDGFRB Recombinant antibody
Activity: Measured by its binding ability in a functional ELISA. Immobilized Human PDGFRB (CSB-MP017713HU1) at 2 μg/mL can bind Anti-PDGFRB recombinant antibody. The EC50 is 2.471-2.776 ng/mL. -
IHC image of CSB-RA017713MA1HU diluted at 1:50 and staining in paraffin-embedded human placenta tissue performed on a Leica BondTM system. After dewaxing and hydration, antigen retrieval was mediated by high pressure in a citrate buffer (pH 6.0). Section was blocked with 10% normal goat serum 30min at RT. Then primary antibody (1% BSA) was incubated at 4°C overnight. The primary is detected by a Anti-Human lgG, Fcy Fragment Specific labeled by HRP and visualized using 0.05% DAB.
-
IHC image of CSB-RA017713MA1HU diluted at 1:50 and staining in paraffin-embedded human testis tissue performed on a Leica BondTM system. After dewaxing and hydration, antigen retrieval was mediated by high pressure in a citrate buffer (pH 6.0). Section was blocked with 10% normal goat serum 30min at RT. Then primary antibody (1% BSA) was incubated at 4°C overnight. The primary is detected by a Anti-Human lgG, Fcy Fragment Specific labeled by HRP and visualized using 0.05% DAB.
-
-
其他:
產品詳情
-
Uniprot No.:
-
基因名:
-
別名:Beta platelet derived growth factor receptor antibody; Beta-type platelet-derived growth factor receptor antibody; CD 140B antibody; CD140 antigen-like family member B antibody; CD140b antibody; CD140b antigen antibody; IBGC4 antibody; IMF1 antibody; JTK12 antibody; OTTHUMP00000160528 antibody; PDGF R beta antibody; PDGF Receptor beta antibody; PDGF-R-beta antibody; PDGFR 1 antibody; PDGFR antibody; PDGFR beta antibody; PDGFR1 antibody; PDGFRB antibody; PGFRB_HUMAN antibody; Platelet derived growth factor receptor 1 antibody; Platelet derived growth factor receptor beta antibody; Platelet derived growth factor receptor beta polypeptide antibody
-
反應種屬:Human
-
免疫原:Recombinant Human PDGFRB protein
-
免疫原種屬:Homo sapiens (Human)
-
標記方式:Non-conjugated
-
克隆類型:Monoclonal
-
抗體亞型:hIgG4
-
純化方式:Affinity-chromatography
-
克隆號:11H3
-
濃度:It differs from different batches. Please contact us to confirm it.
-
保存緩沖液:Preservative: 0.03% Proclin 300
Constituents: 50% Glycerol, 0.01M PBS, PH 7.4 -
產品提供形式:Liquid
-
應用范圍:ELISA, IHC
-
推薦稀釋比:
Application Recommended Dilution ELISA 1:5000-1:50000 IHC 1:50-1:200 -
Protocols:
-
儲存條件:Upon receipt, store at -20°C or -80°C. Avoid repeated freeze.
-
貨期:Basically, we can dispatch the products out in 1-3 working days after receiving your orders. Delivery time maybe differs from different purchasing way or location, please kindly consult your local distributors for specific delivery time.
-
用途:For Research Use Only. Not for use in diagnostic or therapeutic procedures.
相關產品
靶點詳情
-
功能:Tyrosine-protein kinase that acts as cell-surface receptor for homodimeric PDGFB and PDGFD and for heterodimers formed by PDGFA and PDGFB, and plays an essential role in the regulation of embryonic development, cell proliferation, survival, differentiation, chemotaxis and migration. Plays an essential role in blood vessel development by promoting proliferation, migration and recruitment of pericytes and smooth muscle cells to endothelial cells. Plays a role in the migration of vascular smooth muscle cells and the formation of neointima at vascular injury sites. Required for normal development of the cardiovascular system. Required for normal recruitment of pericytes (mesangial cells) in the kidney glomerulus, and for normal formation of a branched network of capillaries in kidney glomeruli. Promotes rearrangement of the actin cytoskeleton and the formation of membrane ruffles. Binding of its cognate ligands - homodimeric PDGFB, heterodimers formed by PDGFA and PDGFB or homodimeric PDGFD -leads to the activation of several signaling cascades; the response depends on the nature of the bound ligand and is modulated by the formation of heterodimers between PDGFRA and PDGFRB. Phosphorylates PLCG1, PIK3R1, PTPN11, RASA1/GAP, CBL, SHC1 and NCK1. Activation of PLCG1 leads to the production of the cellular signaling molecules diacylglycerol and inositol 1,4,5-trisphosphate, mobilization of cytosolic Ca(2+) and the activation of protein kinase C. Phosphorylation of PIK3R1, the regulatory subunit of phosphatidylinositol 3-kinase, leads to the activation of the AKT1 signaling pathway. Phosphorylation of SHC1, or of the C-terminus of PTPN11, creates a binding site for GRB2, resulting in the activation of HRAS, RAF1 and down-stream MAP kinases, including MAPK1/ERK2 and/or MAPK3/ERK1. Promotes phosphorylation and activation of SRC family kinases. Promotes phosphorylation of PDCD6IP/ALIX and STAM. Receptor signaling is down-regulated by protein phosphatases that dephosphorylate the receptor and its down-stream effectors, and by rapid internalization of the activated receptor.
-
基因功能參考文獻:
- EBF1-PDGFRB is sufficient to drive leukemogenesis. PMID: 28555080
- Study demonstrated that LRIG2 promoted the PDGFRBinduced proliferation of glioblastoma multiforme cells in vitro and in vivo through regulating the PDGFRB signalingmediated cell cycle progression. PMID: 30015847
- High expression of PDGFR-beta in prostate cancer stroma is independently associated with clinical and biochemical prostate cancer recurrence. PMID: 28233816
- Study investigated the more detailed mechanism for this cis-interaction of Necl-5 with the PDGF receptor beta. Necl-5 contains three Ig-like domains and the PDGF receptor beta contains five Ig-like domains at their extracellular regions; showed that the third Ig-like domain of Necl-5 cis-interacted with the fifth Ig-like domain of the PDGF receptor beta. PMID: 29431243
- Study revealed that high PDGFRbeta expression in cancer tissue was an independent marker of poor prognosis relating to recurrence in patients with colorectal cancer. PMID: 29498405
- Melatonin reinforces the anticancer activity of sorafenib by downregulation of PDGFR-beta/STAT3 signaling pathway and melatonin receptor (MT)-mediated STAT3. PMID: 29953970
- High GLI2 or PDGFRB expression is associated with unfavorable survival in GC patients. GLI2 can induce PDGFRB expression in GC cells via directly binding to its promoter. In addition, the GLI2-PDGFRB axis might be an important signaling pathway modulating CSC properties of GC cells. PMID: 28975979
- The cell surface PDGFRB is a major link between high glucose and its effectors Hif1a and TGFB for induction of diabetic mesangial cell hypertrophy. PMID: 28951244
- describes three unique PDGFRB fusions in childhood B- or T-ALL. All three PDGFRB fusion partners have previously been reported to be implicated in hematopoiesis and immune responses PMID: 28552906
- These findings indicated that miR-518b may function as a tumor suppressor by targeting PDGFRB in the occurrence and development of GBM. PMID: 28849154
- Data show that an equilibrium mixture of two unusual end-insertion G-quadruplexes forms in a native promoter sequence and appears to be the molecular recognition for platelet derived growth factor receptor beta (PDGFR-beta) downregulation. PMID: 29288770
- Case Report: heterozygous PDGFRB mutation in a family presenting with multicentric autosomal dominant infantile myofibromatosis. PMID: 28417142
- anlotinib inhibits the activation of VEGFR2, PDGFRbeta and FGFR1 as well their common downstream ERK signaling PMID: 29454091
- PDGFRB is not a major causative gene of primary familial brain calcification in Chinese population. PMID: 28298627
- These findings indicate that the levels of phosphorylated PDGFR-beta are decreased in endothelial progenitor cells with the in vitro expansion process, which impairs their angiogenic potential by inhibiting PI3K/Akt signaling. PMID: 28487975
- This review showed that PDGFRB was one of the common gene involved included with brain calcification PMID: 28162874
- Data indicate a positive association between LETM1 up-regulation, YAP1 nuclear localization and high PDGFB expression. PMID: 27556512
- This is the first report of a Korean family that carries a PDGFRB mutation potentially responsible for supernumerary premolars. Our results demonstrate the power of next-generation sequencing in rapidly determining the genetic aetiology of numerical tooth abnormalities. PMID: 28393601
- Genetic analyses indicated a platelet derived growth factor receptor beta (PDGFRB) gene missense heterozygous germline mutation in a newborn boy, and his sister suffered from skull base tumor with same genotype and histology. PMID: 28183292
- Here we report on a special case of a Ph-like acute lymphoblastic leukemia patient who had a variant ATF7IP/PDGFRB fusion. In this case, a variant fusion was created between ATF7IP exon 9 (instead of exon 13) and PDGFRB exon 11, resulting in the loss of 411 nucleotides and 137 amino acids in the ATF7IP/PDGFRB fusion cDNA and its encoded chimeric protein, respectively. PMID: 29133777
- Data show that MLLT11/AF1q-induced PDGFR signaling enhanced STAT3 activity through Src kinase activation. PMID: 27259262
- In conclusion, a specific class of mutations in PDGFRB causes a clinically recognizable syndromic form of skeletal overgrowth. PMID: 28639748
- Suggest the association of activation of Akt-mTOR pathway proteins and PDGFR-beta in fibrosarcomatous transformation of dermatofibrosarcoma protuberans. PMID: 28711648
- High PDGFRB expression is associated with gastric cancer. PMID: 28423550
- Authors identified gain-of-function PDGFRB mutations in the majority of multifocal infantile myofibromatosis cases, shedding light on the mechanism of disease development, which is reminiscent of multifocal venous malformations induced by TIE2 mutations. PMID: 28334876
- findings not only confirm the important role of R853 in establishing the resistant phenotype of the mutant NDEL1-PDGFRB, but also underline the potential of protein modelling for prediction of sensitivity and resistance to TKI treatment. PMID: 27573554
- A novel mutation in PDGFRB [NM_002609.3:c.1699A > G, p.Lys567Glu] was identified in infantile myofibromatosis patients. PMID: 28286173
- Identify PDGFRbeta as a driver in activating Akt/mTORC1 nexus for high glucose-mediated expression of collagen I (alpha2) in proximal tubular epithelial cells, which contributes to tubulointerstitial fibrosis in diabetic nephropathy. PMID: 28424212
- Higher expression of PDGFR-Beta is related to more serious dural penetration of clival chordomas. PMID: 27506406
- Targeted next-generation DNA sequencing identified PDGFRB alterations in all cases of myopericytomatosis and conventional myopericytoma tested (5 cases each), including mutations in 4 cases of myopericytomatosis (N666K in 3; Y562-R565 deletion in 1 case) and 3 myopericytomas (Y562C, K653E, and splice acceptor deletion in 1 case each), as well as low-level PDGFRB amplification in 2 cases of myopericytomatosis and 4 myoperi PMID: 28505006
- Elevated PDGFRB expression was noted in 20.7% of patients with papillary renal cell carcinoma. PMID: 27989785
- Imatinib in myeloid/lymphoid neoplasms with eosinophilia and rearrangement of PDGFRB in chronic or blast phase PMID: 28725989
- inhibition of any internalization mechanism impaired activation of STAT3 but not of other downstream effectors of PDGFRbeta. PMID: 27980069
- this is the first study reporting apparently somatic recurrent PDGFRB mutations as molecular driver events in the majority of sporadic infantile and adult solitary myofibromas PMID: 27776010
- results demonstrate that miR-9 and miR-200 play opposite roles in the regulation of the vasculogenic ability of triple-negative breast cancer, acting as facilitator and suppressor of PDGFRbeta, respectively PMID: 27402080
- Among 15 childhood ALL patients with EBF1-PDGFRB fusion proteins, the fusion arose from interstitial deletion of 5q33 (n = 11), balanced rearrangement (n = 2), or complex rearrangement (n = 2). PMID: 26872634
- Previously unrecognised associations between renal cell carcinoma survival and the absolute levels, and variability, of perivascular PDGFR-beta. PMID: 27931046
- This study suggested that epithelial-mesenchymal transition process can be triggered by the PDGF-D/PDGFRb axis in tongue squamous cell carcinoma, and then involved in the tumor cell invasion via activation of p38/AKT/ERK/ epithelial-mesenchymal transition pathway. PMID: 27507215
- that a loss of KAI1/CD82 and an increase in PDGFR expression in gliomas relate to a progressive tumor growth PMID: 27764516
- identified PDGFRbeta as a novel marker of stromal activation in oral squamous cell carcinoma; PDGFRbeta was found to be the highest-ranking receptor protein genome-wide PMID: 27128408
- PDGFR-positive myeloid neoplasms are rare. Marked leukocytosis with marked eosinophilia has been rarely described in myeloid neoplasms associated with PDGFR rearrangement. PMID: 28209946
- Stromal expression of PDGFRbeta increased with increasing histologic grade of breast phyllodes tumor. PDGFR stromal positivity was associated with shorter overall survival. PMID: 27881889
- The expression level of PDGFRB in glioblastoma multiforme pericytes from the microvascular proliferation was significantly higher than that in GBM tumor cells. miRNAs targeting PDGFRB were downregulated in microvascular proliferation. PMID: 26857280
- PDGFRB gene rearrangement is associated with transformation from atypical chronic myeloid leukemia to chronic myelomonocytic leukemia. PMID: 26881541
- Results suggested that increased bFGF upregulates the expression of PDGFRbeta and may enhance PDGFRbeta-mediated pericyte functions after brain ischemia PMID: 26569132
- Data suggest that cross-talk between PDGFb-dependent beta-catenin activation and Wnt signaling increases pulmonary artery smooth muscle cell proliferation in idiopathic pulmonary arterial hypertension; proliferation is not increased in normal cells. PMID: 26787464
- The KIT and PDGFRB mutations were predicted to be pathogenic using in silico analysis, whereas the ERBB2 mutation was predicted to be benign.. the patient was treated with pazopanib and achieved a partial response that lasted for 7.5 months PMID: 26483058
- These molecular insights confirm that mutant PDGFRB is indeed the driver mutation in PDGFRB rearranged myeloid neoplasms, consistent with the robust treatment responses with imatinib. PMID: 26662677
- PDGFs could exert their mechanism of action through an autocrine/paracrine effect on granulosa and theca cells mediated by PDGFRs. PMID: 25937181
- Soluble platelet-derived growth factor receptor-beta is a biomarker of brain pericyte injury and blood-brain barrier dysfunction. PMID: 26407747
顯示更多
收起更多
-
相關疾病:Myeloproliferative disorder chronic with eosinophilia (MPE); Leukemia, acute myelogenous (AML); Leukemia, juvenile myelomonocytic (JMML); Basal ganglia calcification, idiopathic, 4 (IBGC4); Myofibromatosis, infantile 1 (IMF1); Kosaki overgrowth syndrome (KOGS); Premature aging syndrome, Penttinen type (PENTT)
-
亞細胞定位:Cell membrane; Single-pass type I membrane protein. Cytoplasmic vesicle. Lysosome lumen. Note=After ligand binding, the autophosphorylated receptor is ubiquitinated and internalized, leading to its degradation.
-
蛋白家族:Protein kinase superfamily, Tyr protein kinase family, CSF-1/PDGF receptor subfamily
-
數據庫鏈接:
Most popular with customers
-
-
YWHAB Recombinant Monoclonal Antibody
Applications: ELISA, WB, IHC, IF, FC
Species Reactivity: Human, Mouse, Rat
-
Phospho-YAP1 (S127) Recombinant Monoclonal Antibody
Applications: ELISA, WB, IHC
Species Reactivity: Human
-
-
-
-
-